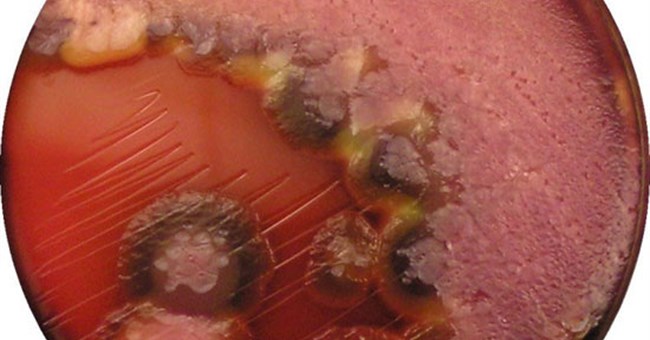
Vi khuẩn Pseudomonas aeruginosa tự di chuyển được

Đọc luôn để nắm được cách "soi" vết cắn, biết ngay con gì đốt

Một ngày đẹp trời, bạn thức dậy và thấy người có những vết mẩn ngứa, mà chắc chắn thủ phạm không phải là muỗi.
Sở thích quái đản của vị Hoàng đế trẻ tuổi bậc nhất Trung Hoa

Mỗi tháng, vị hoàng đế này chỉ thượng triều một lần. Thậm chí có những khi ông để mặc cho các đại thần chờ đến tận trưa rồi mới cho thái giám đến thông báo không lâm triều.
Người đàn ông xây bãi đáp UFO theo lệnh người ngoài hành tinh

Bãi đáp UFO (vật thể bay không xác định) xếp từ những khối đá màu trắng và nâu xếp theo hình ngôi sao mang tên ovniport xuất hiện ở thị trấn nhỏ Cachi thuộc tỉnh Salta, Argentina.
Tập đoàn Kalashnikov sản xuất xe máy điện đi 1km chỉ tốn 172 đồng tiền điện

Trong khuôn khổ diễn đàn quân sự quốc tế "Army-2018" đang diễn ra tại Nga, chúng ta có thể bắt gặp rất nhiều nguyên mẫu thú vị được đem ra triển lãm.
Sự sống trên Trái đất thực sự bắt đầu khi nào?

Khoảng 3,9 tỷ năm trước - ngay sau khi trái đất bị hành tinh Theia tấn công và trong khi nó vẫn còn phải đối mặt với một loạt các thiên thạch - tổ tiên của tất cả những sinh vật sống đã được sinh ra.
7 sự thật về Trái đất mà rất nhiều người trong chúng ta vẫn chưa kịp cập nhật

Trải qua hàng ngàn năm, chúng ta vẫn chưa thể nào hiểu hết được về hành tinh Xanh. Lý do đơn giản là vì qua thời gian, mọi thứ đều thay đổi.
Loài nhện “quăng tơ” bắt mồi y hệt như cao bồi miền viễn tây

Nhện Bolas là một bậc thầy về nghệ thuật săn mồi. Danh hiệu này có được là do loài nhện này đã biết kết hợp một cách hoàn hảo giữa mưu mẹo và kỹ năng tóm gọn con mồi đỉnh cao của mình.
Phân của trẻ sơ sinh – nguồn lợi khuẩn dồi dào!

Các nhà khoa học tại Trường Y học Wake Forest đã cho chuột ăn vi khuẩn từ phân của trẻ sơ sinh, và cho thấy kết quả tốt trong sức khỏe đường ruột của chúng.
8 cách hạ men gan đơn giản ai cũng có thể làm được

Men gan là một phần cuộc sống của chúng ta, sở dĩ nói như vậy là vì men gan có chức năng chuyển hóa các chất dinh dưỡng, loại bỏ độc tố, giúp cơ thể khỏe mạnh.
Bóng siêu bền không xẹp dù bị xe tải cán

Bóng One World Futbol được làm từ một loại mút đặc biệt, không cần bơm hơi và có thể sử dụng nhiều năm.
Ở trong phòng có nhiệt độ thấp có thể là một nguyên nhân gây ra bệnh huyết áp cao

Theo một nghiên cứu mới của Đại học College London đăng trên tạp trí Hypertension hôm thứ 3, nhiệt độ phòng thấp có liên quan đến nguy cơ mắc bệnh huyết áp cao.
Thượng nghị sĩ John McCain mắc ung thư não thể nguy hiểm nhất

Khối u glioblastoma xuất phát từ não hoặc tủy sống nên di căn nhanh, chưa có cách điều trị, thời gian sống của bệnh nhân trung bình 14 tháng.
Giải mã 6 tiếng động bất thường trong máy bay

Khi đang ở trong một chiếc máy bay cách mặt đất hơn 10.000m, bất kỳ tiếng động có vẻ khác thường nào phát ra, cũng có thể khiến bạn lo lắng.
 Bạn có tin không, giấy - loại vật liệu lâu đời và quá đỗi quen thuộc với chúng ta hàng ngày sẽ trở nên vô cùng thú vị khi chúng có thể tự uốn, gập, tạo hình theo lệnh.
Bạn có tin không, giấy - loại vật liệu lâu đời và quá đỗi quen thuộc với chúng ta hàng ngày sẽ trở nên vô cùng thú vị khi chúng có thể tự uốn, gập, tạo hình theo lệnh. Cảnh đẹp thiên nhiên và di tích cổ tại Hàn Quốc vô cùng ấn tượng. Sau đây là phong cảnh nhiều nơi trên đất nước này, không riêng ở thủ đô Seoul.
Cảnh đẹp thiên nhiên và di tích cổ tại Hàn Quốc vô cùng ấn tượng. Sau đây là phong cảnh nhiều nơi trên đất nước này, không riêng ở thủ đô Seoul. Các nhà khoa học của Viện Nghiên cứu y khoa tại Garvan, Sydney, Úc, đã phát hiện ra một cấu trúc mới trong cơ thể con người, ghi nhớ cách chống nhiễm trùng và chỉ xuất hiện khi người bị phát bệnh.
Các nhà khoa học của Viện Nghiên cứu y khoa tại Garvan, Sydney, Úc, đã phát hiện ra một cấu trúc mới trong cơ thể con người, ghi nhớ cách chống nhiễm trùng và chỉ xuất hiện khi người bị phát bệnh. Theo Ladbible, đoạn video bắt đầu với hình ảnh con cá voi lưng gù bơi bên dưới mặt nước một cách bình thường.
Theo Ladbible, đoạn video bắt đầu với hình ảnh con cá voi lưng gù bơi bên dưới mặt nước một cách bình thường. Hiện nay, Việt Nam đã sản xuất được 8/10 loại vaccine trong chương trình tiêm chủng mở rộng quốc gia.
Hiện nay, Việt Nam đã sản xuất được 8/10 loại vaccine trong chương trình tiêm chủng mở rộng quốc gia. Cá Sư tử (hay còn được gọi là mao tiên biển) là loài cá đẹp, được giới nuôi cá nước mặn rất ưa thích.
Cá Sư tử (hay còn được gọi là mao tiên biển) là loài cá đẹp, được giới nuôi cá nước mặn rất ưa thích. Theo lương y Bùi Hồng Minh, Phó Chủ tịch Hội Đông y Ba Đình, Hà Nội, ho là phản ứng của cơ thể để bài tiết những dị vật ra ngoài cơ thể và làm sạch đường hô hấp
Theo lương y Bùi Hồng Minh, Phó Chủ tịch Hội Đông y Ba Đình, Hà Nội, ho là phản ứng của cơ thể để bài tiết những dị vật ra ngoài cơ thể và làm sạch đường hô hấp Một ngày đẹp trời, bạn thức dậy và thấy người có những vết mẩn ngứa, mà chắc chắn thủ phạm không phải là muỗi.
Một ngày đẹp trời, bạn thức dậy và thấy người có những vết mẩn ngứa, mà chắc chắn thủ phạm không phải là muỗi. Mỗi tháng, vị hoàng đế này chỉ thượng triều một lần. Thậm chí có những khi ông để mặc cho các đại thần chờ đến tận trưa rồi mới cho thái giám đến thông báo không lâm triều.
Mỗi tháng, vị hoàng đế này chỉ thượng triều một lần. Thậm chí có những khi ông để mặc cho các đại thần chờ đến tận trưa rồi mới cho thái giám đến thông báo không lâm triều. Bãi đáp UFO (vật thể bay không xác định) xếp từ những khối đá màu trắng và nâu xếp theo hình ngôi sao mang tên ovniport xuất hiện ở thị trấn nhỏ Cachi thuộc tỉnh Salta, Argentina.
Bãi đáp UFO (vật thể bay không xác định) xếp từ những khối đá màu trắng và nâu xếp theo hình ngôi sao mang tên ovniport xuất hiện ở thị trấn nhỏ Cachi thuộc tỉnh Salta, Argentina. Trong khuôn khổ diễn đàn quân sự quốc tế "Army-2018" đang diễn ra tại Nga, chúng ta có thể bắt gặp rất nhiều nguyên mẫu thú vị được đem ra triển lãm.
Trong khuôn khổ diễn đàn quân sự quốc tế "Army-2018" đang diễn ra tại Nga, chúng ta có thể bắt gặp rất nhiều nguyên mẫu thú vị được đem ra triển lãm. Khoảng 3,9 tỷ năm trước - ngay sau khi trái đất bị hành tinh Theia tấn công và trong khi nó vẫn còn phải đối mặt với một loạt các thiên thạch - tổ tiên của tất cả những sinh vật sống đã được sinh ra.
Khoảng 3,9 tỷ năm trước - ngay sau khi trái đất bị hành tinh Theia tấn công và trong khi nó vẫn còn phải đối mặt với một loạt các thiên thạch - tổ tiên của tất cả những sinh vật sống đã được sinh ra. Trải qua hàng ngàn năm, chúng ta vẫn chưa thể nào hiểu hết được về hành tinh Xanh. Lý do đơn giản là vì qua thời gian, mọi thứ đều thay đổi.
Trải qua hàng ngàn năm, chúng ta vẫn chưa thể nào hiểu hết được về hành tinh Xanh. Lý do đơn giản là vì qua thời gian, mọi thứ đều thay đổi. Nhện Bolas là một bậc thầy về nghệ thuật săn mồi. Danh hiệu này có được là do loài nhện này đã biết kết hợp một cách hoàn hảo giữa mưu mẹo và kỹ năng tóm gọn con mồi đỉnh cao của mình.
Nhện Bolas là một bậc thầy về nghệ thuật săn mồi. Danh hiệu này có được là do loài nhện này đã biết kết hợp một cách hoàn hảo giữa mưu mẹo và kỹ năng tóm gọn con mồi đỉnh cao của mình. Các nhà khoa học tại Trường Y học Wake Forest đã cho chuột ăn vi khuẩn từ phân của trẻ sơ sinh, và cho thấy kết quả tốt trong sức khỏe đường ruột của chúng.
Các nhà khoa học tại Trường Y học Wake Forest đã cho chuột ăn vi khuẩn từ phân của trẻ sơ sinh, và cho thấy kết quả tốt trong sức khỏe đường ruột của chúng. Men gan là một phần cuộc sống của chúng ta, sở dĩ nói như vậy là vì men gan có chức năng chuyển hóa các chất dinh dưỡng, loại bỏ độc tố, giúp cơ thể khỏe mạnh.
Men gan là một phần cuộc sống của chúng ta, sở dĩ nói như vậy là vì men gan có chức năng chuyển hóa các chất dinh dưỡng, loại bỏ độc tố, giúp cơ thể khỏe mạnh. Bóng One World Futbol được làm từ một loại mút đặc biệt, không cần bơm hơi và có thể sử dụng nhiều năm.
Bóng One World Futbol được làm từ một loại mút đặc biệt, không cần bơm hơi và có thể sử dụng nhiều năm. Theo một nghiên cứu mới của Đại học College London đăng trên tạp trí Hypertension hôm thứ 3, nhiệt độ phòng thấp có liên quan đến nguy cơ mắc bệnh huyết áp cao.
Theo một nghiên cứu mới của Đại học College London đăng trên tạp trí Hypertension hôm thứ 3, nhiệt độ phòng thấp có liên quan đến nguy cơ mắc bệnh huyết áp cao. Khối u glioblastoma xuất phát từ não hoặc tủy sống nên di căn nhanh, chưa có cách điều trị, thời gian sống của bệnh nhân trung bình 14 tháng.
Khối u glioblastoma xuất phát từ não hoặc tủy sống nên di căn nhanh, chưa có cách điều trị, thời gian sống của bệnh nhân trung bình 14 tháng. Khi đang ở trong một chiếc máy bay cách mặt đất hơn 10.000m, bất kỳ tiếng động có vẻ khác thường nào phát ra, cũng có thể khiến bạn lo lắng.
Khi đang ở trong một chiếc máy bay cách mặt đất hơn 10.000m, bất kỳ tiếng động có vẻ khác thường nào phát ra, cũng có thể khiến bạn lo lắng.